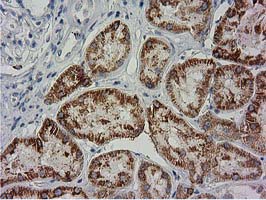

| Western blot (WB): | 1:500~2000 |
| Immunohistochemistry (IHC): | 1:150 |
| Immunocytochemistry/Immunofluorescence (ICC/IF): | 1:100 |
| Flow cytometry (FCM): | 1:100 |

Immunohistochemical staining of paraffin-embedded Human liver tissue within the normal limits using anti-BECN1 mouse monoclonal antibody. (Heat-induced epitope retrieval by 10mM citric buffer, pH6.0, 100°C for 10min, M00327-3)

Western blot analysis of extracts (35ug) from 9 different cell lines by using anti-BECN1 monoclonal antibody (HepG2: human; HeLa: human; SVT2: mouse; A549: human; COS7: monkey; Jurkat: human; MDCK: canine; PC12: rat; MCF7: human).

Immunohistochemical staining of paraffin-embedded Human Kidney tissue within the normal limits using anti-BECN1 mouse monoclonal antibody. (Heat-induced epitope retrieval by 10mM citric buffer, pH6.0, 100°C for 10min, M00327-3)

HEK293T cells transfected with either overexpress plasmid (Red) or empty vector control plasmid (Blue) were immunostained by anti-BECN1 antibody, and then analyzed by flow cytometry.

Immunohistochemical staining of paraffin-embedded Adenocarcinoma of Human breast tissue using anti-BECN1 mouse monoclonal antibody. (Heat-induced epitope retrieval by 10mM citric buffer, pH6.0, 100°C for 10min, M00327-3)

Anti-BECN1 mouse monoclonal antibody immunofluorescent staining of COS7 cells transiently transfected by pCMV6-ENTRY BECN1 .

HEK293T cells were transfected with the pCMV6-ENTRY control (Left lane) or pCMV6-ENTRY BECN1 (Right lane) cDNA for 48 hrs and lysed. Equivalent amounts of cell lysates (5 ug per lane) were separated by SDS-PAGE and immunoblotted with anti-BECN1.

Immunohistochemical staining of paraffin-embedded Human liver tissue within the normal limits using anti-BECN1 mouse monoclonal antibody. (Heat-induced epitope retrieval by 10mM citric buffer, pH6.0, 100°C for 10min, M00327-3)

Western blot analysis of extracts (35ug) from 9 different cell lines by using anti-BECN1 monoclonal antibody (HepG2: human; HeLa: human; SVT2: mouse; A549: human; COS7: monkey; Jurkat: human; MDCK: canine; PC12: rat; MCF7: human).

Immunohistochemical staining of paraffin-embedded Human Kidney tissue within the normal limits using anti-BECN1 mouse monoclonal antibody. (Heat-induced epitope retrieval by 10mM citric buffer, pH6.0, 100°C for 10min, M00327-3)

HEK293T cells transfected with either overexpress plasmid (Red) or empty vector control plasmid (Blue) were immunostained by anti-BECN1 antibody, and then analyzed by flow cytometry.

Immunohistochemical staining of paraffin-embedded Adenocarcinoma of Human breast tissue using anti-BECN1 mouse monoclonal antibody. (Heat-induced epitope retrieval by 10mM citric buffer, pH6.0, 100°C for 10min, M00327-3)

Anti-BECN1 mouse monoclonal antibody immunofluorescent staining of COS7 cells transiently transfected by pCMV6-ENTRY BECN1 .

HEK293T cells were transfected with the pCMV6-ENTRY control (Left lane) or pCMV6-ENTRY BECN1 (Right lane) cDNA for 48 hrs and lysed. Equivalent amounts of cell lysates (5 ug per lane) were separated by SDS-PAGE and immunoblotted with anti-BECN1.